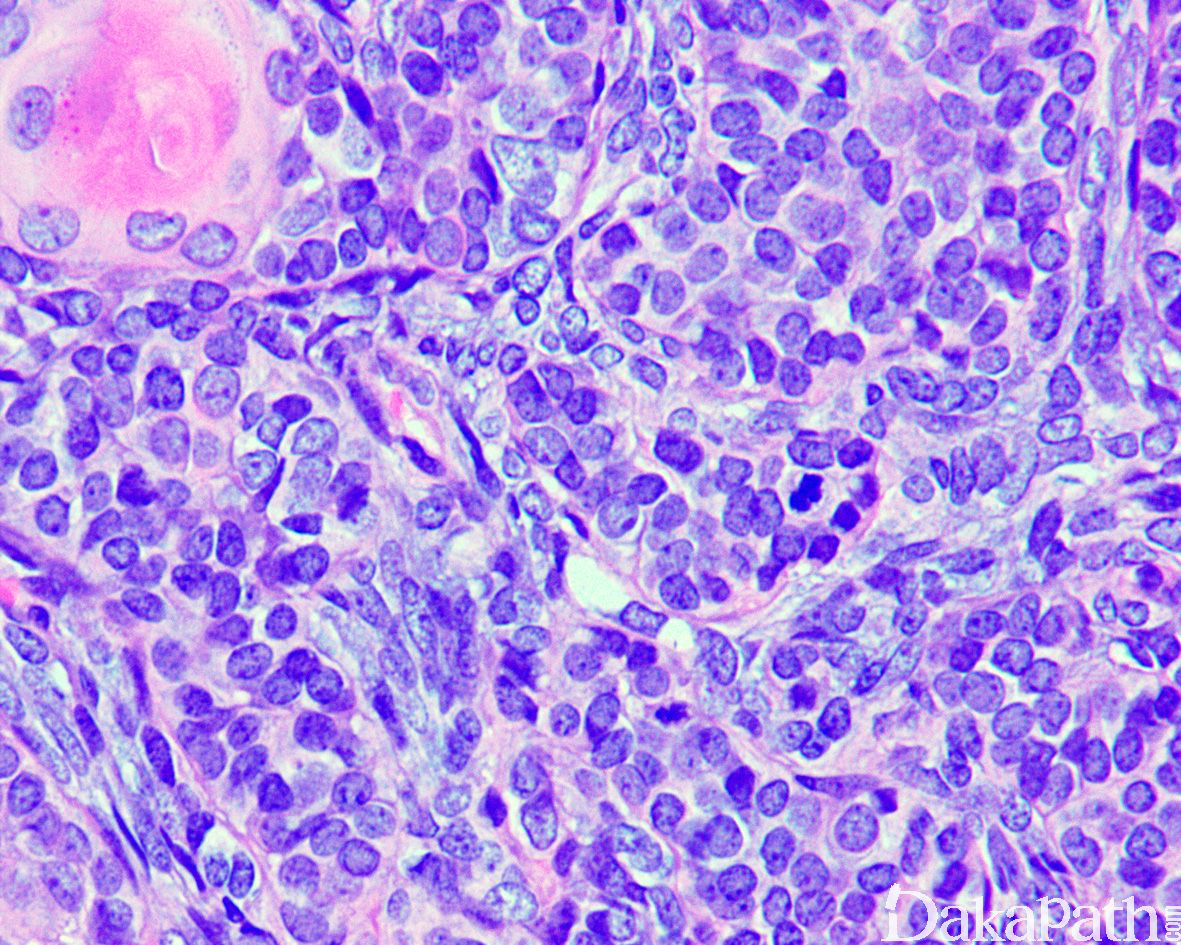

高分化型滑膜肉瘤
Well differentiated synovial sarcoma
同义词(或曾用名): 腱鞘滑膜肉瘤,滑膜细胞肉瘤,恶性滑膜瘤,滑膜母细胞性肉瘤
概述:
滑膜肉瘤(Synovial Sarcoma)是软组织较常见的恶性肿瘤,具有间叶和上皮双相性分化。
发病部位: 多见于 15-20 岁青壮年,男性稍多于女性;多发生于四肢大关节附近,以下肢膝关节最多;
诊断要点:
多见于 15-20 岁青壮年,男性稍多于女性;多发生于四肢大关节附近,以下肢膝关节最多;
肿瘤呈结节状或分叶状,多数界限较清晰,可见纤维性假包膜,部分肿瘤与周围肌腱、腱鞘或关节囊外壁相连,切面灰白或灰红,鱼肉状,可伴有出血坏死、囊性变;
双向分化明显,上皮样瘤细胞和梭形瘤细胞分化均较成熟;
梭形细胞呈长梭形,似成纤维细胞,排列成束状、旋涡状或编织状、血管外皮瘤样结构排列;
上皮样瘤细胞多为扁平的内皮细胞样,衬于裂隙的表面,可排列成腺样、管状、梁索状;
两种细胞之间可见过渡和移行,未见典型基膜。
免疫组织化学染色:上皮性标志物抗体:CK、EMA、CK7. CK8. CK14. CK18. CK19 阳性;间叶性标志物抗体:VIM 阳性;不同程度表达 CD99. S100. SMA、calponin、h-caldesmon、MSA;CD34. desmin 多不表达;
细胞遗传学:t(X;18)(p11;q11)染色体易位、SYT-SSX1\2\4 融合。
免疫组织化学染色:
上皮性标志物抗体:CK、EMA、CK7. CK8. CK14. CK18. CK19 阳性;间叶性标志物抗体:VIM 阳性;不同程度表达 CD99. S100. SMA、calponin、h-caldesmon、MSA;上皮细胞和间叶性细胞表达 TFE-1;CD34. desmin 多不表达;
分子标记:
SYT-SSX1\2\4 融合
鉴别诊断:
肉瘤样癌:癌性成分和肉瘤样成分均具有明显的异型性和多形性,而滑膜肉瘤的瘤细胞多形性较轻微,具有相似的胞浆和染色质纹理,互相逐渐过渡和移行。
参考文献:
← 外周原始神经外胚层瘤家族 淀粉样瘤 →